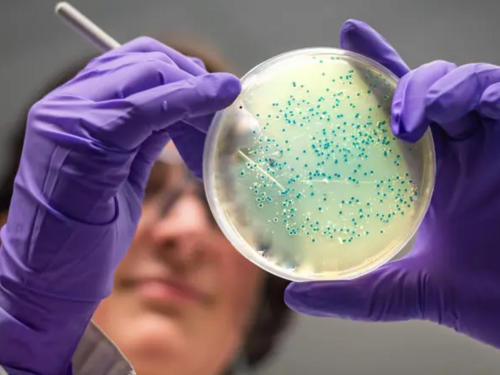
Vještačka inteligencija pronašla antibiotike za gonoreju i MRSA superbakterije

Ljepota i Zdravlje
Vještačka inteligencija pronašla antibiotike za gonoreju i MRSA superbakterije
Vještačka inteligencija osmislila je dva nova potencijalna antibiotika koja bi mogla zaustaviti infekcije izazvane MRSA bakterijom i gonorejom otpornom na lijekove, otkrili su naučnici.